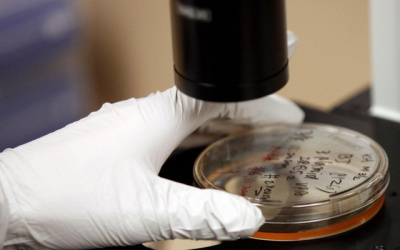
Chữa rối loạn cương bằng... tế bào gốc

Cảnh báo nguy cơ liệt chân vì thói quen ngồi khoanh chân kéo dài
26/04/2026 09:46
Một nam sinh viên 19 tuổi tại Thái Nguyên bất ngờ rơi vào tình trạng tê yếu chân, dáng đi bất...
Chất lượng chế độ ăn quyết định nguy cơ mắc Alzheimer
25/04/2026 13:24
Một nghiên cứu quy mô lớn kéo dài hơn một thập kỷ cho thấy, không phải mọi chế độ ăn...
Thời tiết cả nước dịp nghỉ lễ Giỗ Tổ Hùng Vương và 30/4-1/5 thế nào?
24/04/2026 17:03
29/03/2017 15:33
Dù mới 2 tuổi nhưng Ruben Storey được mệnh danh là "nông dân trẻ nhất nước Anh". Cậu bé tỏ ra vô cùng nhiệt tình với việc đồng áng và còn giúp mẹ đỡ đẻ cho cừu.
29/03/2017 14:40
Mặc dù 74% học sinh nói rằng sợ căn bệnh ung thư, 50% lo ngại mình sẽ mắc ung thư nhưng tất cả đều đánh giá thấp vai trò của chế độ ăn uống cũng như vận động trong phòng ngừa ung thư.
29/03/2017 14:33
Ngày 29/3, Bệnh viện Phụ sản Hùng Vương TP.HCM vừa chính thức đưa vào sử dụng máy chụp nhũ ảnh kỹ thuật số, đây là thiết bị hiện đại, lần đầu tiên triển khai trong hệ thống...
29/03/2017 14:33
Tết Hàn thực của người Việt rơi vào ngày 3/3 Âm lịch hàng năm, với ý nghĩa hướng về cội nguồn, tưởng nhớ tới công ơn dưỡng dục của những người đã khuất.
29/03/2017 10:47
Sự việc xảy ra với một chuyến bay dân dụng của hãng hàng không Đức TUI Fly khi phi công của máy bay ngất xỉu giữa hành trình, buộc nữ tiếp viên phải thay thế để cứu cả phi hành đoàn...
29/03/2017 10:23
Một bệnh nhân trong lúc truyền đạm tại bệnh viện Đa khoa huyện Nông Cống (Thanh Hóa) đã bị sốc phản vệ. Sau khi được bệnh viện cấp cứu qua cơn nguy kịch, bệnh nhân tiếp tục tái...
28/03/2017 17:21
Theo Trung tâm Dự báo Khí tượng Thủy văn Trung ương, trong 2 ngày tới, miền Bắc tiếp tục ấm lên trước khi đón một đợt không khí lạnh vào cuối tuần.
28/03/2017 16:32
Một bước đột phá trong nghiên cứu tế bào gốc đã giúp những nam giới bị rối loạn cương sau phẫu thuật tuyến tiền liệt có cơ hội được có lại một đời sống tình dục bình...
28/03/2017 16:27
Phát triển ở cả hệ thống y tế công lập tuyến cơ sở và nhân rộng sang y tế tư nhân, song đến nay nhiều phòng khám bác sĩ gia đình gần như không có người bệnh. Ngoài những yếu kém về...
28/03/2017 16:19
Theo thông tin từ Trung tâm Chống độc - Bệnh viện Bạch Mai, đã có một bệnh nhân trong vụ ngộ độc nấm rừng đã tử vong. Hiện các bác sỹ vẫn đang theo dõi sức khỏe của các bệnh nhân còn...